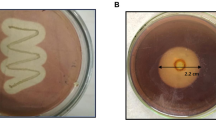

Abstract
Microfiltration (MF) and ultrafiltration (UF) membranes were screened for improving the specific activity of polygalacturonases (PG) in the culture broth of Aspergillus carbonarius obtained after submerged fermentation. While 200 and 450 nm MF membranes eliminated some of the larger non-enzymatic proteins, 50 kDa UF membrane exhibited a marginal selectivity between the enzyme and other smaller proteins. The 450 nm MF and 50 kDa UF membranes selected were further evaluated under different process conditions for an integrated membrane process. The process efficacy of three different schemes was also studied for enzyme purification. A two-stage membrane process employing MF followed by UF improved the enzyme-specific activity (5,590 U/mg) by 4.69-fold eliminating the larger and smaller non-enzymatic proteins as well as non-protein impurities with a recovery of 76% enzymes, besides resulting in higher productivity. Thus, adoption of integrated membrane process with appropriate selection of membranes could result in high recovery of enzymes with improved specific activity.
Similar content being viewed by others
Explore related subjects
Discover the latest articles, news and stories from top researchers in related subjects.Avoid common mistakes on your manuscript.
Introduction
Microorganisms produce a mixture of metabolites during fermentation. Since the fermented media contain high amounts of contaminating proteins along with other media components like carbohydrates and salts, downstream processing requires purification and concentration of the target molecule for application. In the case of microbial enzymes produced as secondary metabolites, culture broth processing using membranes have been in vogue on a commercial scale since 1970s owing to their convenience. Membrane processes have largely replaced or complemented some of the traditional downstream processing methods [1, 2].
Pectinases have several applications in food, paper, and textile industries. In the industrial market, microbial pectinases that contribute to almost 25% of the global food enzyme sales [3] is estimated to increase further [4]. In order to meet the demand, membrane purification of enzymes appears both cost effective and efficient. Although use of porous membranes [microfiltration/ultrafiltration (MF/UF)] for concentration and purification of microbial pectinases has been reported [5–9], the protocols for their use were in conjunction with other known methods.
Sathish-Kumar and Palanivelu [7] employed a 450 nm MF membrane for the purification of an extracellular PG enzyme from Thermomyces lanuginosus and reported reduced specific activity (16 U/mg) with 0.69-fold purity and 44% recovery. With subsequent acetone precipitation and ion-exchange chromatography, the authors achieved a specific activity of 131 U/mg with an overall recovery of 13%. Gainvors et al. [8] reportedly purified an acidic endo-PG from Saccharomyces cerevisiae by UF (30 kDa; 4.8-fold, specific activity 15.5 U/mg, recovery 83%) followed by acetone precipitation and anion exchange chromatography (specific activity 2,534 U/mg, overall recovery 6%). Silva et al. [9] included a pre-treatment step with kaolin while purifying Penicillium viridicatum exo-PG for improving UF performance (10 kDa; 7.7-fold, specific activity 1,000 U/mg, recovery 28%). Further size exclusion chromatography improved the specific activity (1,400 U/mg) while resulting in reduced recovery (7%). Although there have been contributions to the use of membranes for enzyme purification, its potential has not been completely exploited to achieve greater purity as well as recovery. Therefore, it is necessary to focus on intensive membrane-based approaches towards purification of desired enzymes from the application viewpoint for the industrial scale production [10].
In an earlier study [11], we reported near complete elimination of carbohydrates, salts, and acids from A. carbonarius culture broth containing PG with 96% recovery using a 10 kDa UF membrane. The protocol developed improved the enzyme activity from 4.6 to 49.4 U/mg of dry matter mainly by eliminating interfering carbohydrates that affect concentration processes such as lyophilization and precipitation [3]. These carbohydrates also trap enzymes during cold storage.
This investigation describes selection of a combination of membranes for the removal of larger and smaller non-enzymatic proteins from A. carbonarius culture broth containing PG to obtain greater enzyme-specific activity as well as recovery. The integrated membrane process approach proposed would have positive impact on the operational size and cost in the subsequent enzyme purification steps.
Materials and Methods
Chemicals
Galacturonic acid and bovine serum albumin (BSA) were procured from M/s Sigma Chemicals, USA. Detergent (P3-Ultrasil 10) was purchased from M/s Henkel Hygiene GmbH, Germany. Other analytical and laboratory grade chemicals used for the study were procured from reputed companies in India. Corn flour was purchased from the local market.
Organism
A mutant A. carbonarius, deposited at the culture collection centre of the Food Microbiology Department, CFTRI under the accession number UV 10046, was used. The fungus was grown at 30°C in a medium made of 2.5% (w/v) corn flour and 0.313% (w/v) diammoniumhydrogen phosphate and ammoniumdihydrogen phosphate. For aeration, the flasks were kept on a rotary platform shaker (200 rpm). The 48 h culture broth was separated from the mycelia by filtration through muslin cloth, and pH was adjusted to 4.0 using 0.1 M sodium hydroxide. Prior to membrane processing, the debris and spores were removed by filtration through Whatman no.1 filter paper.
Membranes
Hydrophilic amphoteric nylon 6,6 MF membranes of pore size 200 and 450 nm were procured from M/s Pall Pharmalab Filtration, India. Hydrophilic UF membranes with polysulphone (MWCO 500, 100, 50, and 25 kDa) and polyethersulphone (MWCO 10 kDa) as active layer/coating and polypropylene as support layer (Danish Separation Systems AS, Denmark) were obtained from the National Food Research Institute, Tsukuba, Japan. For use with the self-stirred flat membrane cell (Cat. No. XFUF04701, Millipore), MF and UF membranes were cut into circular discs (4.7 cm diameter and 15 cm2 effective area) and fitted in such a way that the active surface was in contact with the feed material.
Membrane Filtration System
Experiments were conducted at room temperature under nitrogen atmosphere. Pressure applied depended on the type of membrane process (MF, 0.1 MPa; UF, 0.5 MPa) and was adjusted using the regulator of the nitrogen cylinder. To minimize concentration polarization effect, the contents in the cell were stirred on a magnetic stirrer (800 rpm). The unit was operated in batch mode by charging the cell with 50 ml culture broth. The experimental run was stopped upon achieving the desired volume concentration ratio (VCR). Flux corresponded to the actual measurement or average of the measurements of permeates collected every 30 min. Pure water flux was also measured before processing the culture broth. Membranes were cleaned with 0.25% (w/v) detergent followed by 0.1 N sodium hydroxide and 400 mg/kg sodium hypochlorite solutions for 30 min each. The recovery of original water flux was the criterion followed for membrane reuse after cleaning.
The unit was also operated in discontinuous diafiltration mode of operation with 100% dilution in two steps after the primary run. Initially, the cell was charged with 50 ml culture broth and processed until a VCR of 10 was reached. Then the retentate fraction was diluted with 25 ml of 0.85% NaCl solution (for maintaining protein stability) and the experimental run was continued as before and stopped upon permeation of same quantity as that of addition (25 ml). This was continued until the desired number of steps of diafiltration was achieved.
Performance Parameters
The performance of the membrane process was expressed as percentage observed rejection (R o) of each component. R o was determined assuming that it was constant for each batch experiment [12]. Other performance parameters of MF and UF were determined as follows:
-
Microfiltration
-
Ultrafiltration
Where C F, C P and C R are the enzyme activity (U/ml) or protein content (μg/ml) or carbohydrate content (mg/ml) or phosphate salts (mg/ml) or total acids (mg/ml) in feed, permeate and retentate. V F, V P and V R are the volume of feed, permeate and retentate (ml), respectively.
Overall enzyme recovery and elimination of proteins, carbohydrates, salts and acids in the multi-step process were estimated with reference to the crude culture broth.
Enzyme Assay
PG activity was determined using 0.5% polygalacturonic acid (sodium salt) prepared in 0.1 M sodium acetate buffer (pH 4.3) as substrate. Assays were carried out for 10 min at 50°C and the reducing sugars were quantified as galacturonic acid equivalents according to Nelson–Somogyi method [13]. Activity corresponded to µmol galacturonic acid released per minute.
Estimation of Protein
Protein content was determined by the dye binding method [14] using Coomassie brilliant blue G 250. Bovine serum albumin was used as standard.
Estimation of Total Carbohydrates, Inorganic Phosphate and Total Acids
Total carbohydrate was determined by the phenol-sulphuric acid method using dextrose as standard [15]. Inorganic phosphate content was determined by the Ames method [16] using potassiumdihydrogen phosphate as standard. Total acids were determined as titrable acidity using 0.1 N sodium hydroxide [17].
Results and Discussion
Earlier experiments using several UF membranes (10, 25, 100, and 500 kDa) showed that the 10 kDa membrane in diafiltration operation removed most of the carbohydrates, phosphate salts, and total acids from A. carbonarius culture broth with a higher PG recovery [11]. Although the protocol was effective in eliminating non-protein impurities, there was practically no improvement in the enzyme specific activity since contaminating proteins were also recovered along with the enzyme. Therefore, an integrated process employing MF and UF membranes was attempted to purify PG with preprocessed as well as crude culture broths.
Elimination of Larger Non-enzymatic Proteins by MF
MF membranes with two different pore sizes (200 and 450 nm) were tested for their ability to eliminate larger non-enzymatic proteins from culture broth centrifuged and diafiltered using 10 kDa UF membrane (Table 1). Lower PG rejection than contaminating proteins by both the membranes resulted in 1.38–1.40-fold improved specific activity of the enzyme in the permeate stream. This revealed that some of the larger non-enzymatic proteins were eliminated employing MF. Although the pattern of protein rejection was similar, the rejection of PG enzyme was lower with 450 nm compared to 200 nm membrane resulting in higher specific activity of PG (4,440 U/mg). Elimination of non-enzymatic proteins, higher recovery of PG enzyme (75%) and greater productivity [37 l/(m2·h)] obtained using 450 nm membrane suggested its further evaluation for the integrated membrane process.
The performance of 450 nm membrane was examined with diluted feed and also in diafiltration mode of operation. The feed diluted to 400% resulted in 73% PG recovery compared to 65% recovery obtained with undiluted feed. However, the purity reduced from 1.48- to 1.11-fold. Increasing the dilution to 900% (close to original culture broth concentration) enabled 85% PG recovery without affecting purification (Fig. 1). Diafiltration resulted in higher purity (1.28-fold) with 82% PG recovery. Reduction in productivity during diafiltration was due to lower flux [21 l/(m2·h)] compared to the run using diluted feed [220 l/(m2·h)]. The need for appropriate process conditions while purifying PG from A. carbonarius culture broth described above probably explains the low enzyme purity (0.69-fold) and recovery (44%) reported by Sathish-Kumar and Palanivelu [7] processing the culture broth of T. lanuginosus PG using a similar pore size MF membrane.
Elimination of Smaller Non-enzymatic Proteins by UF
Processing with UF membranes (25, 50, 100, and 500 kDa MWCO) showed elimination of contaminating proteins from the preprocessed culture broth (Table 2). Least and highest retention of PG as well as proteins apparently without any selectivity was recorded with the 500 and 25 kDa membranes, respectively. The retention performance of 100 and 50 kDa UF membranes was in between the above membranes. Greater specific activity (3,530 U/mg) and improved enzyme purity (1.11-fold) obtained in the retentate stream of 50 kDa membrane suggested its selectivity for PG. The results revealed that some of the contaminating proteins were smaller than the A. carbonarius PG of molecular weights 42 and 61 kDa [3] that could be eliminated to a limited extent with the 50 kDa UF membrane. Suitability of the membrane was also evidenced by 86% recovery and 21 l/(m2·h) flux. Therefore, the 50 kDa UF membrane was evaluated further for employing along with MF in an integrated membrane process for processing A. carbonarius PG.
Diluting the feed improved the purity as well as recovery of PG enzyme and higher the dilution greater was the improvement (Fig. 2). Processing 900% diluted feed improved the enzyme purity by 1.29-fold with a high recovery of 96%. The productivity [44 l/(m2·h)] was also much higher compared to undiluted feed. During diafiltration, enzyme purity (1.21-fold), recovery (63%), and productivity [20 l/(m2·h)] were lower compared to the above run with diluted feed.
Integrated Membrane Processing of Culture Broth
Based on the results described above, three different schemes were attempted for processing A. carbonarius culture broth employing membranes for the purification of PG.
Purification of PG (CF–UF–MF–UF)
In Scheme-1, PG purification involved a centrifugation (CF) step for clarifying the culture broth followed by sequential processing through 10 kDa UF, 450 nm MF, and 50 kDa UF membranes (Table 3). The first two steps were employed for pre-processing the crude culture broth to eliminate non-protein impurities as described earlier [11]. Processing the above culture broth after suitable dilution through 450 nm MF membrane eliminated 21% larger contaminating proteins. This resulted in 1.10-fold increase in enzyme purity. In the subsequent UF (50 kDa), 54% contaminating proteins (smaller) were eliminated with diafiltration resulting in improved specific activity (2,350 U/mg). Diafiltration in this stage seemed to help achieve higher purity by eliminating more non-enzymatic proteins without sacrificing the enzyme recovery (94%). The scheme eliminated 62% total protein while retaining 78% enzymes with a specific activity of 2,350 U/mg (Table 3). It also resulted in a higher PG activity of 248 U/mg dry solids as against 19 U/mg dry solids of the preprocessed culture broth. The results showed that the majority of the contaminating proteins in the culture broth, amenable for membrane separation, were predominantly <50 kDa and some were >450 nm. Since only 1.98-fold enzyme purity was obtained, modifications were attempted to improve the process efficacy.
Purification of PG (UF–MF–UF)
CF competes with MF many a time in process applications and at times is used as a pre-treatment to MF/UF. In Scheme-2, CF was excluded since MF is also capable of removing suspended solids. The 10 kDa retentate when processed after suitable dilution using 450 nm MF membrane improved the enzyme purity to 1.39-fold owing to the elimination of 40% larger contaminating proteins (Table 3). The higher purity obtained could be due to secondary layer formation on the membrane surface due to adsorption and deposition of substances contained in the feed [18, 19] that aid in the rejection of non-enzymatic proteins while allowing smaller molecular enzymes. The exclusion of CF reduced the permeate flux during MF, probably due to concentration polarization, fouling and secondary layer formation. However, PG recovery (84%) was comparable to 87% obtained after MF in Scheme-1. In the final UF with diafiltration using 50 kDa membrane, 68% proteins (smaller) were eliminated leading to PG with a specific activity of 6,120 U/mg (Table 3). The higher PG recovered (95%) compensated the lower recovery obtained during MF. The scheme also resulted in 246 U/mg dry solid comparable to that obtained in Scheme-1 despite starting with a lower activity of 11.4 U/mg dry solids.
Though the overall PG recovery (76%) was similar to that obtained with Scheme-1, elimination of 82% total proteins improved specific activity by 5.14-fold (1.98-fold obtained with Scheme-1). Based on the above results, another scheme was attempted in order to further reduce the process steps.
Purification of PG (MF–UF)
The 10 kDa UF membrane processing of the crude culture broth, which removed non-protein impurities, was deleted in Scheme-3 on the assumption that diafiltration using 50 kDa membrane can also aid their removal along with non-enzymatic proteins. To test the hypothesis, crude culture broth containing PG was filtered through Whatman no. 1 filter paper and directly processed in a two step membrane process with 450 nm MF and 50 kDa UF membranes (Table 3). During MF, 45% larger contaminating proteins were eliminated leading to 1.50-fold increase in enzyme purity and 85% recovery. The performance was comparable with MF step in Scheme-2 except for a small decline in the permeate flux. Diafiltration with 50 kDa UF membrane eliminated 65% contaminating proteins (smaller). It was also effective in eliminating non-protein impurities, carbohydrates (96%), and almost total phosphate salts and acids. The final specific activity and recovery of the enzyme achieved in this scheme were also comparable with the values obtained in Scheme-2. It also resulted in a higher PG activity of 247 U/mg dry solids as that of the other two schemes even though the starting value was much lower (2.6 U/mg dry solids in crude culture broth). The overall performance achieved with Scheme-3 was significant since only two steps were involved that offered ~50% reduction in process time and lesser handling volume (Table 3).
In this study, membranes could be reused for several experimental runs (~200 h of operation) after cleaning. Although durability of the membrane was not assessed in terms of its replacement time, such membranes are expected to give a long life in this kind of service environment.
Conclusions
The study revealed that the 450 nm MF and 50 kDa UF membranes were capable of selectively eliminating contaminating proteins from the culture broth of A. carbonarius containing PG taking advantage of the differences in their molecular sizes. Performance wise, the integrated membrane process was also superior compared to that reported for membrane purification of PG from culture broth [7–9]. Though the results describe the development of an integrated membrane process for purification and recovery of PG from A. carbonarius culture broth, it appears easily adaptable in downstream processing of any microbial culture broth. Besides, this approach would bring down the size and cost of the subsequent purifications steps.
References
O’Sullivan, T. J., Epstein, A. C., Korchin, S. R., & Beaton, N. C. (1984). Chemical Engineering Progress, 68–75, January.
Hwang, K. J., & Hwang, H. C. (2006). Separation and Purification Technology, 51, 416–423.
Singh, S. A., Ramakrishna, M., & Appu Rao, A. G. (1999). Process Biochemistry, 35, 411–417.
Tari, C., Gogus, N., & Tokatli, F. (2007). Enzyme and Microbial Technology, 40, 1108–1116.
Bohdziewicz, J., & Bodzek, M. (1994). Process Biochemistry, 29, 99–107.
Spagna, G., & Pifferi, P. G. (1994). Food Chemistry, 50, 343–349.
Sathish-Kumar, S., & Palanivelu, P. (1999). World Journal of Microbiology & Biotechnology, 15, 643–646.
Gainvors, A., Nedjaoum, N., Gegnies, S., Muzart, M., Nedjma, M., & Belarbi, A. (2000). FEMS Microbiology Letters, 183, 131–135.
Silva, D., Martins, E. S., Leite, R. S. R., Silva, R. D., Ferreira, V., & Gomes, E. (2007). Process Biochemistry, 42, 1237–1243.
Enzyme Bioprocess Technology. Available from: www.novozymes.com. Accessed July 17, 2007.
Nakkeeran, E., Venkatesh, K. S., Subramanian, R., & Umesh Kumar, S. (2008). Journal of Chemical Technology and Biotechnology, (in press) DOI 10.1002/jctb.1895.
Cheryan, M. (1998). Ultrafiltration and microfiltration handbook. Lancaster, PA: Technomic.
Somogyi, M. (1952). Journal of Biological Chemistry, 195, 19–23.
Spector, T. (1978). Analytical Biochemistry, 86, 142–146.
Rao, P., & Pattabiraman, T. N. (1989). Analytical Chemistry, 181, 18–22.
Ames, B. N. (1966). In E. F. Neufeld, & V. Ginsburg (Eds.) Methods in enzymology, vol. 8: complex carbohydrates pp. 115–118. NY: Academic Press.
Ranganna, S. (2003). Handbook of analysis and quality control for fruit and vegetable products (2nd ed.). New Delhi, India: Tata McGraw-Hill Publishing Company Limited.
van Oers, C. W., Vorstman, M. A. G., & Kerkhof, P. J. A. M. (1995). Journal of Membrane Science, 107, 173–192.
Barhate, R. S., Subramanian, R., Nandini, K. E., & Umesh Hebbar, H. (2003). Journal of Food Engineering, 60, 49–54.
Acknowledgements
E. Nakkeeran thanks CSIR, New Delhi, India, for the award of fellowship. H. Nabetani at NFRI, Japan provided the membranes. G. Vijayalakshmi and N. Kumaresan at CFTRI provided valuable advice.
Author information
Authors and Affiliations
Corresponding author
Rights and permissions
About this article
Cite this article
Nakkeeran, E., Subramanian, R. & Umesh Kumar, S. Improving Specific Activity of Aspergillus carbonarius Polygalacturonase Using Polymeric Membranes. Appl Biochem Biotechnol 151, 233–243 (2008). https://doi.org/10.1007/s12010-008-8182-7
Received:
Accepted:
Published:
Issue Date:
DOI: https://doi.org/10.1007/s12010-008-8182-7